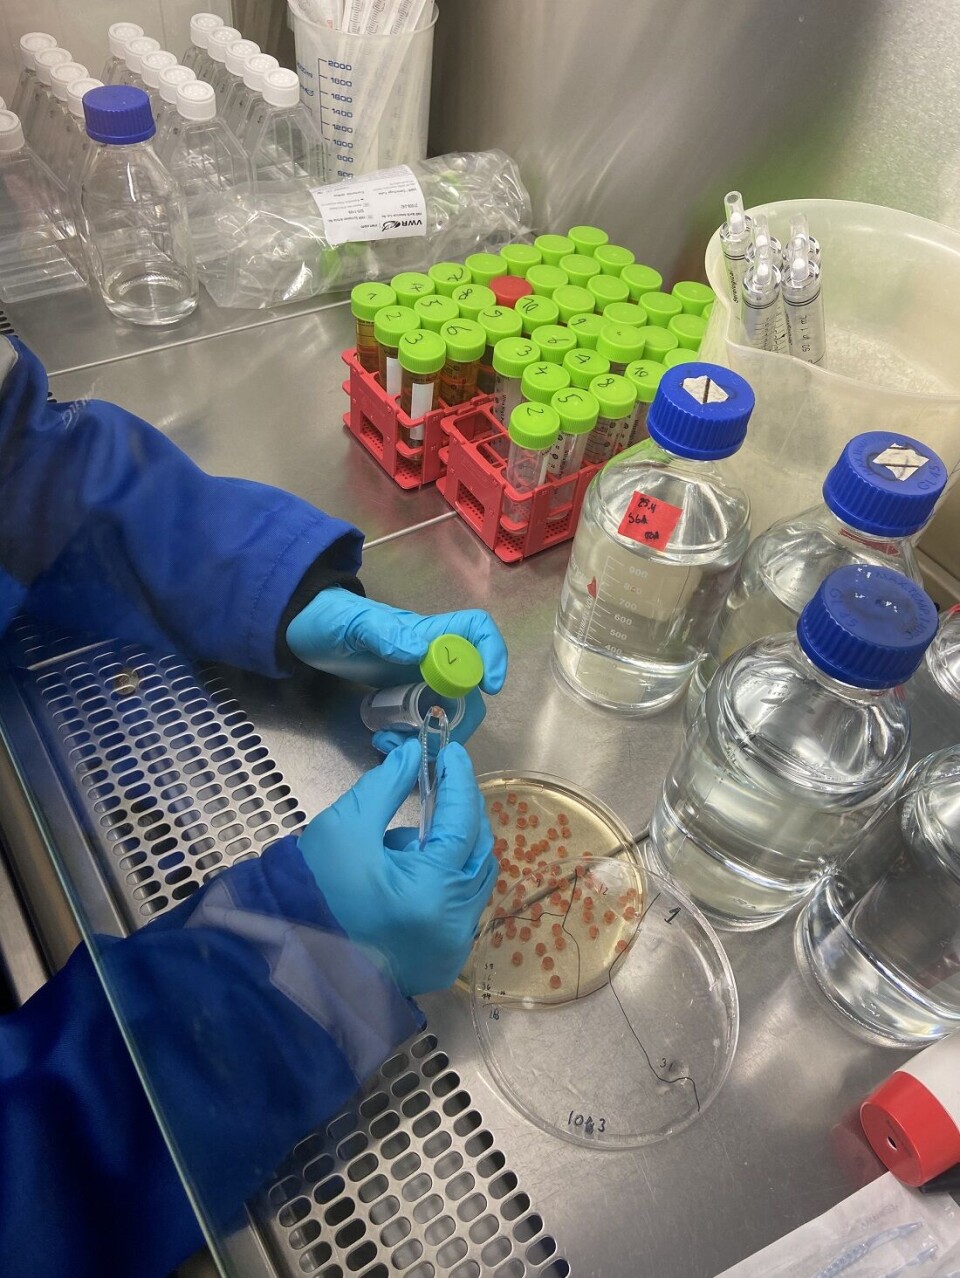

THIS ARTICLE/PRESS RELEASE IS PAID FOR AND PRESENTED BY NTNU Norwegian University of Science and Technology - read more

Bacteria could make salmon healthier
Bacteria-free fish fry put researchers on the track of how they could make fish more resistant to diseases.
Researchers are breeding bacteria-free fish fry. Fry refers to an early developmental stage of fish, typically when they start eating on their own. This pursuit is more important than you might think.
“We’re managing to keep the fry bacteria-free for up to 12 weeks after the eggs hatch,” Ingrid Bakke says. She is a professor at NTNU’s Department of Biotechnology and Food Science.
This step has now helped researchers on the trail of figuring out how bacteria and fish affect each other. Understanding their interaction could one day also lead to a method for preventing the fish from becoming ill, although there is still a long way to go. This could be good news for the fishing industry, our future food supply – and not least for the fish themselves.

The researchers have studied how bacteria affect the growth, genes, and mucous membranes of the fish.
But first, let's talk a little about the bacteria in your body.
Trillions of bacteria
Bacteria obviously affect our health, but not only in a negative way.
As long as we are inside our mother’s womb, we live protected and perhaps even germ-free, but that ends as soon as we are born. A human body normally contains many trillions of bacteria – that’s a number followed by 15 zeros. The same applies to other living organisms.
“Many of our bacteria are necessary for the human body to function. They’re necessary for the development of our immune system, and they contribute to digestion and increase the energy value of the food we eat. They protect against disease bacteria and produce vitamins that we need,” Bakke says.
All these functions help us understand the importance of finding out more about how our bacterial friends work.
So how do researchers go about doing this research?
Knowledge from model systems
“A lot of what we know about how bacteria affect the host organism comes from experiments with model systems,” Bakke says.
But what does that actually mean?
Model systems are living organisms that are easy to work with when studying biological processes. Most often, these species are easy to breed, cheap to maintain, have a reasonably long life cycle, have genetic traits that are easy to manipulate, and other favourable features.
The specific characteristics researchers look for mostly depend on what they want to study. Zebrafish, banana flies and different kinds of mice and rats are among the most well-known species used as model systems.
Bakke and her colleagues have chosen a different species this time: Atlantic salmon.
Bacteria-free salmon fry
Salmon fry go through a stage where they live with a pouch called a yolk sac. This yolk sac supplies nutrition for the fry.
“We’ve come up with a model system where we can keep the yolk sac of the salmon fry bacteria free throughout the 12-week yolk sac phase,” Bakke says.
Fish are normally free from bacteria in the egg phase, but are colonised by bacteria as soon as they hatch. In contrast to all other salmon, these bred fry have no natural bacterial community.
Rresearchers breed the fish in a protected, germ-free environment, a standard method for making bacteria-free salmon fry. The research group has come up with an efficient and effective method that works for salmon eggs and fry.
“We surface treat the fish eggs to keep them bacteria free and keep the eggs, and later the fry, in bacteria-free water,” Bakke says.
Knowing how to create bacteria-free fry is necessary for the group to research them afterwards.

Salmon are like blank slates
The bacteria-free fry become almost like a kind of blank slate where the researchers can add the bacteria they want and then see exactly what happens, without interference from unknown bacteria.
“Bacteria-free model systems are generally important for understanding interactions between the bacteria and host. An example would be understanding how gut microbiota affect development and health in humans and other mammals,” Bakke says.
The microbiota consist of all the microorganisms found in our whole body or parts of our body.
“We can use bacteria and bacterial communities that we define, and investigate how both the host and bacteria are affected by living together,” she says.
For example, the researchers can investigate which factors control the composition of bacterial flora in the fry. The researchers may then be able to influence the bacterial composition in the fish to avoid negative effects, or they can introduce good effects instead.

Salmon fry well suited for research
Zebrafish have been widely used as a model system in this context. But salmon fry have some characteristics that make them particularly suitable.
“We have large and well-developed fry, which makes them easier to study,” Bakke says.
The fry phase is long enough for the researchers to carry out several types of experiments. Since the fry obtain their nutrition from the yolk sac, the researchers don’t need to add fish feed that could contain microorganisms that disturb the research results. As a bonus, the fry are nice to look at.
Bacteria found to affect skin mucous layer in salmon
To date, the researchers have published one article about their findings, but there are more to come. In the first article, they show that bacteria affect the protective skin mucous layer in the fish.
“The salmon have a protective mucous layer on the surface of their body. It appears that the composition of bacteria might affect the properties of this mucous layer,” Bakke says.
The fry that were not exposed to bacteria developed a thinner mucous layer on the outside of their bodies than the fry that were exposed to the researchers’ specially selected bacteria, or bacteria from a lake.
The bacteria can also affect the fat reserves of the fish. The fry that received bacteria from a lake developed greater fat reserves.

Opens the door to treat fish
The goal of the researchers is to understand which mechanisms affect the composition of the bacterial communities that colonise the fish immediately after hatching.
“We’re looking at how the bacterial communities possibly protect against bacterial infections, and whether it’s possible to influence the early bacterial colonisation of fry,” Bakke says.
Enabling such probiotic treatment would mean that researchers could add live microorganisms to the fish to achieve beneficial effects, such as better health and growth.
“But probiotic treatment on a large scale is still a long way off,” she says.
The Norwegian product Stembiont is already available. This is a probiotic product intended for larger fish.
More research is needed for probiotic use on a larger scale.
Reference:
Gómez de la Torre Canny et al. A novel gnotobiotic experimental system for Atlantic salmon (Salmo salar L.) reveals a microbial influence on mucosal barrier function and adipose tissue accumulation during the yolk sac stage, Frontiers in Cellular and Infection Microbiology, vol. 12, 2023. DOI: 10.3389/fcimb.2022.1068302
Read more content from NTNU:
-
The Nansen Legacy: Uncovering the secrets of the Barents Sea
-
Stressed parents increase the risk of self-harm in adolescents
-
People in the Nordic region are more satisfied with life in big cities than others in the EU
-
Burnout is often caused by factors entirely unrelated to work
-
Many choose unemployment benefits over poorly paid jobs
-
The technology of the future could be made from clay